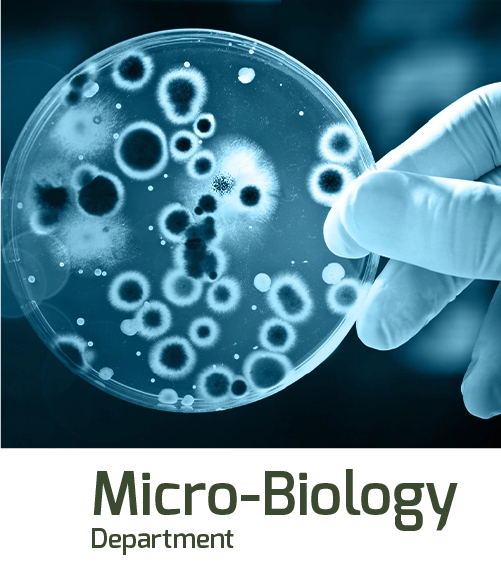

20+ Labs with High-End Latest Technology
100+ Medical Laboratory Technicians
125+ Analyzers Integrated with LIMS
Emergency Help Available 24/7
OUR VISION
To be the nation's top choice for compassionate, convenient, and exceptional laboratory services.
OUR MISSION
To positively impact the healthcare journey of every individual we serve, ensuring Nawaloka Care stands as a symbol of reliability, convenience, and compassionate care, while contributing to a healthier nation.
We Provide All Aspects Of Medical Practice For Your Whole Family!

5
Our Regional Labs
18
Mini Labs
47
Coco's
1000+
Collection Centers
-Let's Check
Our Health Packages
Need a Help for Check-up? Call for an Emergency Laboratory Services
Help Desk 24/7








